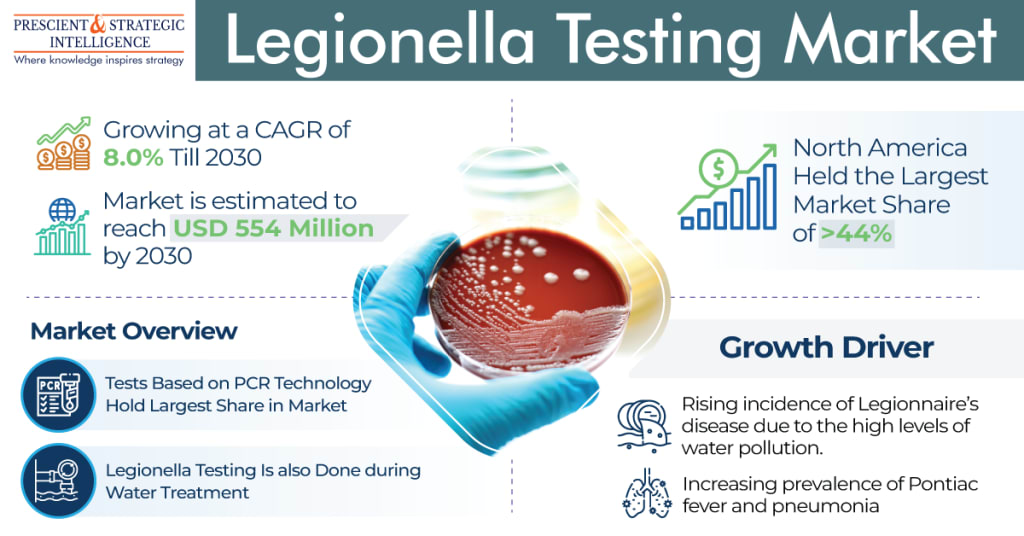

Legionella Testing Industry Was Led by the North American Region
Legionella Testing Analysis
The size of the legionella testing market will power at a rate of 8% in the years to come, reaching USD 554 million by 2030. The major factors which are powering the industry are the growing occurrence of Pontiac fever, Legionnaire’s ailment, and pneumonia.
The industry will grow significantly because of the growth in the elderly populace, as older people are susceptible more than the young people, to infection by this bacterium because of their reduced immunity, along with the fact that they have hypertension, diabetes, chronic kidney disease, and chronic obstructive pulmonary disease.
The PCR category dominated the industry in the past. PCR is the common process put to use for detection of legionella bacteria as it demonstrates the outcomes in one day and is extremely precise, explicit, and sensitive.
Furthermore, PCR might be superior to urinary antigen testing in detecting of this pathogen. Also, a positive PCR for the precise sequence found in the 5S rRNA of legionella specifies the occurrence of its DNA. Moreover, PCR is the most- specific and sensitive method advanced for Legionella pneumophila testing.
So, companies are making use of rapid PCR methods for the detection of legionella. For example, in Jan 2023, EMSL Analytical Inc. introduced rapid PCR and conformist culturing methods for detecting legionella in the environment, for preventing the spread of Legionnaires’ ailment.
On the basis of end user, the diagnostic centers will have the largest share, of over 41%, in the past. This is due to the fact that the increasing consciousness of the early analysis of the ailment, which is growing in prevalence.
In addition to diagnostic centers, the requirement for the associated products amongst water treatment agencies will grow rapidly, because of the growing requirement for onsite testing methods, itself owing to the strict rules on the examination of water before it is supplied to households.
North America legionella testing market had the largest share, of 44%, in 2022, as a result of the growing count of patients with legionella infection and the expansion of the healthcare system. An estimated 8,000–18,000 individuals in the U.S. are admitted to hospitals every year with Legionnaire’s disease.
Europe follows North America, and it will power at a rate of 8.1% by the end of this decade, as a result of the approvals/authorization of testing kits and’ awareness programs of the governments, both of which drive the requirement for the related products.
Due to the increasing occurrence of pneumonia and fever all over the world, the demand for legionella testing will continue to increase in the years to come.
Market Size Breakdown by Segment
Based on Test Type
- Culture Media
- Urine Antigen Testing
- PCR
- Motorized devices
- Non-Motorized devices
- Direct Fluorescent Antibody
Based on Application
- Water Testing
- Microbial Culture
- DFA Stain
- PCR
- IVD Testing
- Blood Culture and Sputum Tests
- Urinary Antigen Test
- DFA Stain
- PCR
Based on End User
- Hospitals and Clinics
- Diagnostic Labs
- Water Treatment Industries
Geographical Analysis
North America
- U.S.
- Canada
Europe
- Germany
- U.K.
- France
- Italy
- Spain
Asia-Pacific
- Japan
- China
- India
- South Korea
- Australia
Latin America
- Brazil
- Mexico
Middle East and Africa
- Saudi Arabia
- South Africa
- U.A.E.
About P&S Intelligence
P&S Intelligence offers custom and syndicated market research and consulting services to clients across the globe. Our team of young and dynamic researchers, guided by mentors with years of experience, create data-rich reports tailored to the needs of MNCs as well as startups and SMEs. We remain in a perennial quest to offer exhaustive insights into every aspect of the market, allowing businesses of all sizes to seize even the smallest of opportunities and tackle even the biggest of challenges.





Comments (1)
This is great work you can also join my friends and read what i have just prepared for you.